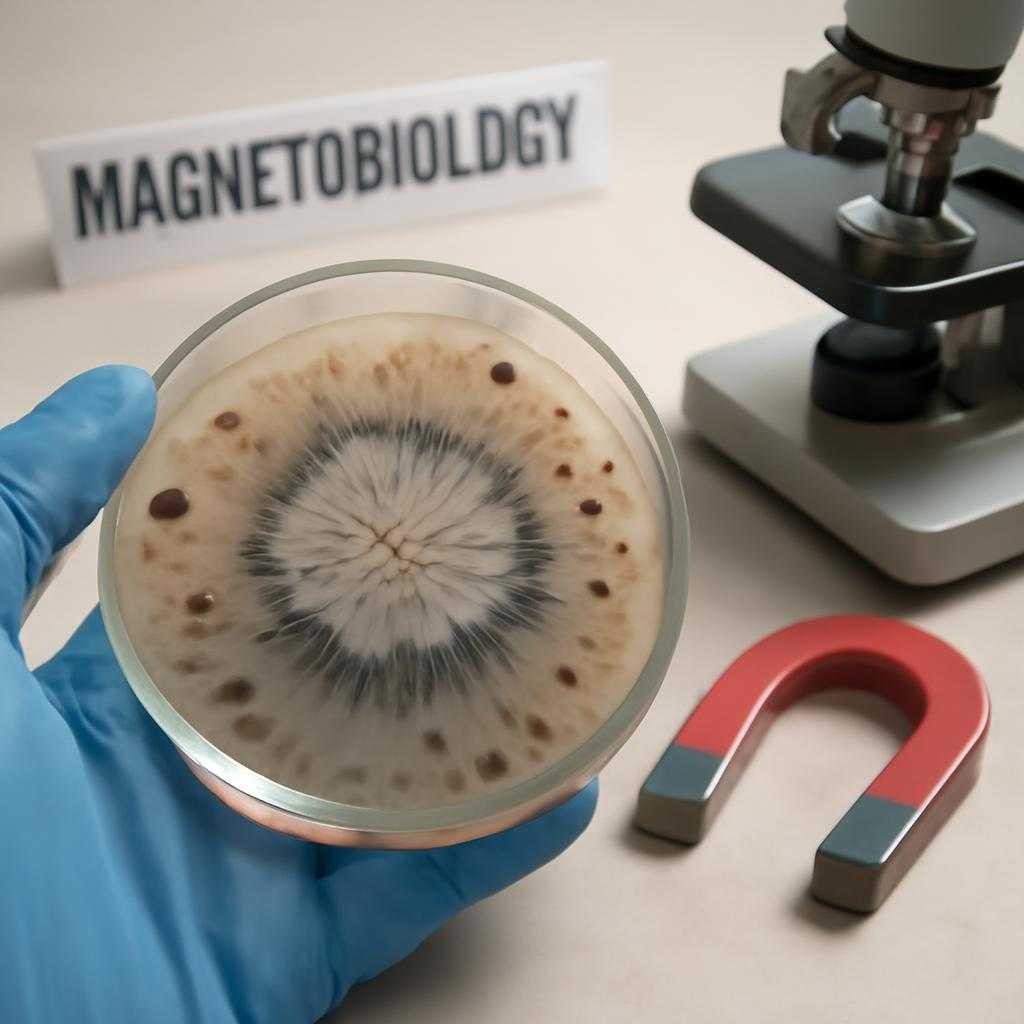
магнитобиология

Смена углового расстояния между планетами фиксируется обсерваторией каждый рассвет. Лента новостей пестрит сообщениями о колебаниях давления у жителей мегаполисов. Корреляция не случайна: орбитальные ритмы влияют на магнитный фон земной среды, а органика реагирует тонко.
Ночные гравитационные приливы
Луна приводит океан к приливу, а внутриклеточную воду к микроскопическому переливу. Исследования института хронобиологии подтвердили, что перигей усиливает подкорковые нейронные каскады, повышая вероятность мигреней. Термин «силенопульс» используется для обозначения частотного сдвига сердечного ритма в эту фазу.
При апогее сосудистый тонус, напротив, понижается: барорецепторы теряют часть привычной нагрузки. Кардиологические сводки рекомендуют держать под рукой растворы для быстрой инфузии натрия.
Солнечные циклы и кровь
На утреннем брифинге гелиофизики сообщили о всплеске протонной активности пятнадцатого цикла. Эритроцитарная мембрана чувствует рост потоков радиации через изменение поверхностного заряда, что приводит к сгущению плазмы. Гематологи фиксируют увеличение вязкости, а значит возрастает риск тромбозов, особенно у пассажиров дальних рейсов.
Помимо радиации солнечный цикл приносит усиление ультрафиолетового излучения. Кожа запускает синтез холекальциферола, сосуды расширяются, но при гиперосмолярном индексе наблюдается всплеск оксидативного стресса. Антиоксидантная защита истончается быстрее у жителей высоких широт.
Венерианские резонансы
Венера хоть и меньше Земли, однако ближний перигелий создаёт электростатический шлейф, пересекающий магнитосферу. Спектры плазменногонных волн на частоте 0,7 Гц синхронизируются с ритмами гипоталамуса. Клиники репродуктивного профиля связывают пик обращений с периодом венерианского максимума. Эндокринологи вводят термин «афродинамика» для описания гормонального отклика.
Профилактическая стратегия включает мониторинг космогеофизических сводок. Ношение браслетов с сенсором вариабельности сердечного ритма помогает отследить ранние сигналы дисбаланса. При выявлении аномалии достаточно пересмотреть график нагрузок и увеличить интервалы отдыха.
В заключении: планетарные циклы образуют сложную партитуру, где каждая нота — гравитация, радиация или электромагнитное колебание — откликается в клетке биохимическим аккордом. Хроноэпидемиология постепенно раскрывает эти созвучия, а медицинская служба новостей продолжит передавать оперативную картину космической погоды.